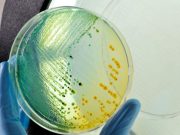
CDC Investigating E. Coli Outbreak in Michigan, Ohio

Day Care Tied to Morbidity in Children Born Preterm With BPD
ED visits, systemic steroid use, chronic respiratory symptoms more likely for children with bronchopulmonary dysplasia who attend day care
CDC Characterizes National Incidence of Fungal Infections
More than 20,000 cases of coccidioidomycosis reported in 2019; 97 percent of cases reported in Arizona and California
CDC Investigating E. Coli Outbreak in Michigan, Ohio
Outbreak has led to nine hospitalizations but no deaths
Nurse-Led Interventions May Cut Children’s Fear of Needles
Divided attention and positive memory reframing are feasible and may reduce vaccine-related distress
Pediatric Populations Less Likely to Get Long COVID
Vaccination tied to lower risk for persistent COVID-19 symptoms at more than 12 weeks since infection
Consensus Developed on Managing Hypertension in Children
Differing positions of current guidelines make the definition and management of arterial hypertension in children and adolescents uncertain
CDC Director Says Agency Needs Major Overhaul
Walensky aims to prioritize public health needs, deemphasize publication of scientific papers about rare diseases
Too Few Psychiatric Beds: Psychiatrists’ Group Takes Aim at Ongoing Crisis
Having enough inpatient beds would cut down on overcrowding in emergency departments
Biden Administration May Stop Buying COVID-19 Vaccines, Treatments by Fall
Tests, vaccines, and treatments would be provided through the regular health care system
Universal Health Care Affects Childhood Vaccination Rates
Countries with greater progress toward UHC had smaller declines in childhood immunization coverage during COVID-19 pandemic